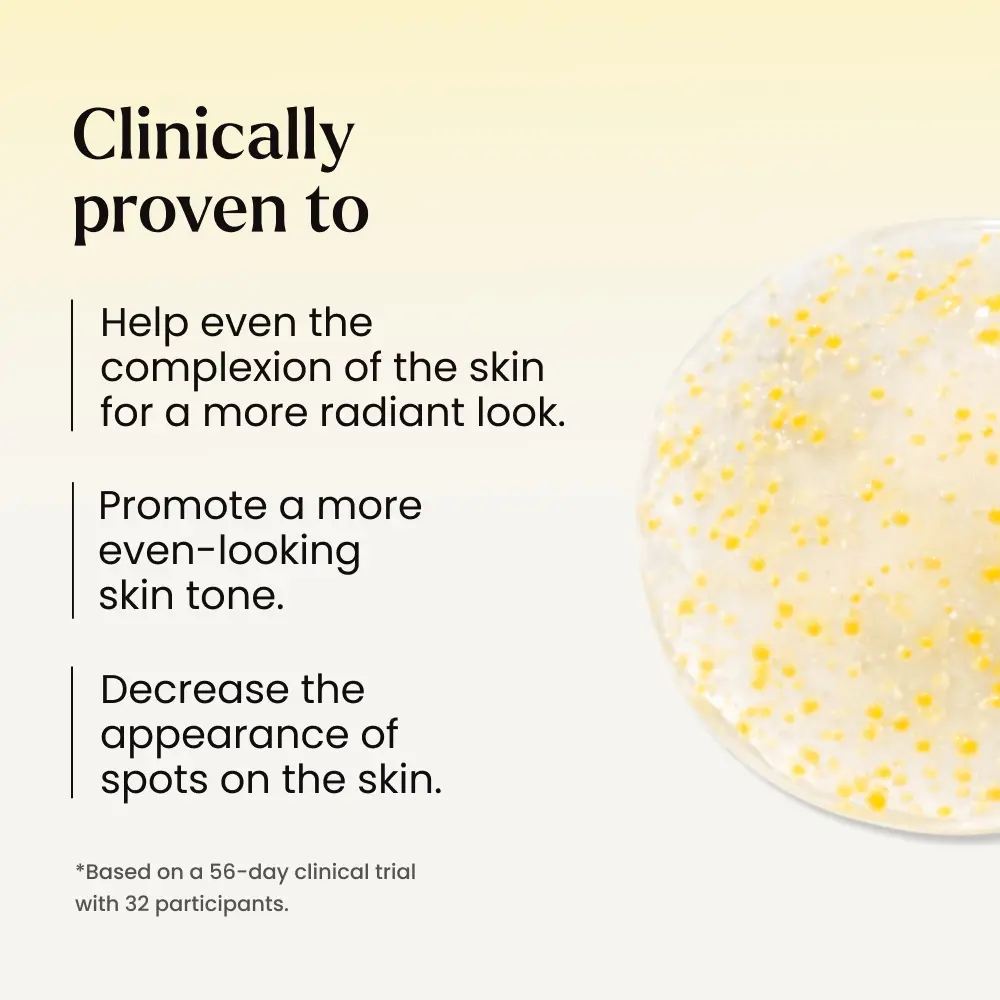

- TikTok Shop
- Beauty & Personal Care
- Bath & Body Care
- Body Moisturizers
- MAËLYS B-GLOWY Clinically Proven Brightening Body Serum - With Niacinamide Body Care Lotions

5
12 global reviews
5
12
4
0
3
0
2
0
1
0
Photos from reviews
Sort by
Recommended
Filter by
All
Displaying 12 of 12 reviews
Reset filters

🌞**h 🩷**
·
Verified purchase
US
Glowy is now my new favorite product! The smell is out of this world, it a little citrus-y/ perfume-y but not too strong. I have photos of before and after of my elbows. This will lighten dark spots and strawberry skin patches. My strawberry skin is a lot so it hasnt cleared yet but it getting better.





Item:
Default2025-07-22
a**4
·
Verified purchase
US
Love this product! I really notice a difference when I use it!

Item:
Default2025-07-09
M**m
·
Verified purchase
US
Love this product ! Instantly can feel
The results it’s my forever must have skin product

Item:
Default2025-02-28
x**a
·
Verified purchase
US
Great product smells really good🫶🏼

Item:
Default2024-07-17
h**c
·
Verified purchase
US
I absolutely love this product

Item:
Default2025-03-12

J**a
·
Verified purchase
US
I just received this product,I’m excited to see if it will help with my brown spots. I already use other products with this brand. If you go to the Maelys website and enter GETMINI you will receive a free mini Get dreamy with your purchase.

Item:
Default2025-03-29

c**s
·
Verified purchase
US
It works well and the smell is amazing.
Item:
Default2025-03-19

A**1
·
Verified purchase
US
Love it makes my skin look amazing !
Item:
Default2024-08-17

🌸**g m**, b**k l**🌸
·
Verified purchase
US
Best!! Highly recommend!!
Item:
Default2025-04-05

P**o
·
Verified purchase
US
Very good product
Item:
Default2024-07-12

M** M**d p**s
·
Verified purchase
US
Item:
Default2024-07-23

S**o
·
Verified purchase
US
Item:
Default2024-04-23
About this product
$62.00
Free shipping
MAËLYS B-GLOWY Clinically Proven Brightening Body Serum - With Niacinamide Body Care Lotions
5(12)
7.3K sold
Specification:Default
Default
Quantity:
Coupon center
Log in to check your coupons
View and claim any available offers once you're logged in.
Shipping & returns
Shipping & delivery
Many items qualify for free shipping or become eligible once the order threshold is met.
Returns made easy
Most items are eligible for free returns within 30 days of delivery for a refund. Some items, including ingestibles, hygiene products, and pre-owned goods, are non-returnable. Final sale items cannot be returned or replaced.

MAËLYS
OFFICIAL SHOP
4.4
405.0K Sold
69.3K+ Followers
99%24h response rate
54%Ships within 2 days
84%Positive feedback
Visit
Shop review
Videos for this product
Creator earns commission
Kanchi
2.2K
Creator earns commission
Sanae USA👑
1.7K
Creator earns commission
Dalila Ramirez
818
Creator earns commission
Selfiequeen
751
Creator earns commission
@mariac
463
Creator earns commission
🌷Ericka Sorto🌺
366
Creator earns commission
Yakylastre
330
MAËLYS
274
🔥🔥YOLANDAROMERO🔥🔥
273
Creator earns commission
Blanca
261
Creator earns commission
Bethy Engdaye 💙🪮
253
Creator earns commission
BRI 💕
225
Creator earns commission
Saul Sabrina
217
Creator earns commission
Kymie Ann
200
Creator earns commission
IrisMarie9187
177
Creator earns commission
Cat
165
Explore more from MAËLYS
People also searched for


















